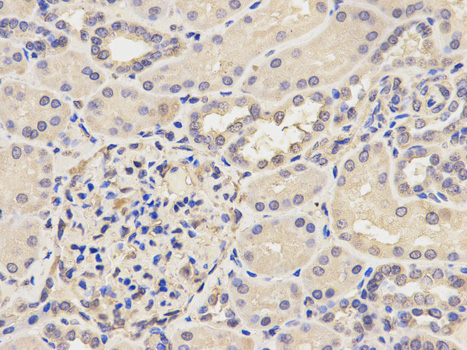
a06544 1 ap2b1 primary antiboties ihc testing 2

Product Info Summary
| SKU: | A06544-1 |
|---|---|
| Size: | 100ul |
| Reactive Species: | Human, Mouse, Rat |
| Host: | Rabbit |
| Application: | IHC, WB |
Customers Who Bought This Also Bought
Product info
Product Name
Anti-AP-2 complex subunit beta AP2B1 Antibody
SKU/Catalog Number
A06544-1
Size
100ul
Form
Liquid
Description
Boster Bio Anti-AP-2 complex subunit beta AP2B1 Antibody catalog # A06544-1. Tested in WB,IHC applications. This antibody reacts with Human,Mouse,Rat.
Storage & Handling
Store at -20°C for one year. For short term storage and frequent use, store at 4°C for up to one month. Avoid repeated freeze-thaw cycles.
Cite This Product
Anti-AP-2 complex subunit beta AP2B1 Antibody (Boster Biological Technology, Pleasanton CA, USA, Catalog # A06544-1)
Host
Rabbit
Contents
Rabbit IgG, 1mg/ml in PBS with 0.02% sodium azide, 50% glycerol, pH7.2
Clonality
Polyclonal
Isotype
IgG
Immunogen
Recombinant fusion protein of human AP2B1(NP_001025177.1).
Cross-reactivity
No cross reactivity with other proteins.
Reactive Species
A06544-1 is reactive to AP2B1 in Human, Mouse, Rat
Calculated molecular weight
104.6 kDa
Antibody Validation
Boster validates all antibodies on WB, IHC, ICC, Immunofluorescence, and ELISA with known positive control and negative samples to ensure specificity and high affinity, including thorough antibody incubations.
Application & Images
Applications
A06544-1 is guaranteed for IHC, WB Boster Guarantee
Recommend Dilution
WB: 1:500-1:2000
IHC: 1:50-1:200
Validation Images & Assay Conditions

Click image to see more details
Western blot analysis of extracts of various cell lines, using AP2B1 antibody at 1:500 dilution.
Secondary antibody: HRP Goat Anti-Rabbit IgG at 1:10000 dilution.
Lysates/proteins: 25ug per lane.
Blocking buffer: 3% nonfat dry milk in TBST.
Detection: ECL Basic Kit .
Exposure time: 10s.
Click image to see more details
Immunohistochemistry of paraffin-embedded human esophagus using AP2B1 Antibody at dilution of 1:100 .Perform microwave antigen retrieval with 10 mM PBS buffer pH 7.2 before commencing with IHC staining protocol.

Click image to see more details
Immunohistochemistry of paraffin-embedded mouse lung using AP2B1 Antibody at dilution of 1:100 .Perform microwave antigen retrieval with 10 mM PBS buffer pH 7.2 before commencing with IHC staining protocol.

Click image to see more details
Immunohistochemistry of paraffin-embedded mouse stomach using AP2B1 Antibody at dilution of 1:100 .Perform microwave antigen retrieval with 10 mM PBS buffer pH 7.2 before commencing with IHC staining protocol.
Specific Publications For Anti-AP-2 complex subunit beta AP2B1 Antibody (A06544-1)
Loading publications
Recommended Resources
Here are featured tools and databases that you might find useful.
- Boster's Pathways Library
- Protein Databases
- Bioscience Research Protocol Resources
- Data Processing & Analysis Software
- Photo Editing Software
- Scientific Literature Resources
- Research Paper Management Tools
- Molecular Biology Software
- Primer Design Tools
- Bioinformatics Tools
- Phylogenetic Tree Analysis
Customer Reviews
Have you used Anti-AP-2 complex subunit beta AP2B1 Antibody?
Share your experimental results or join a short interview to earn up to $1,000 in product credits or other rewards.
0 Reviews For Anti-AP-2 complex subunit beta AP2B1 Antibody
Customer Q&As
Have a question?
Find answers in Q&As, reviews.
Can't find your answer?
Submit your question




